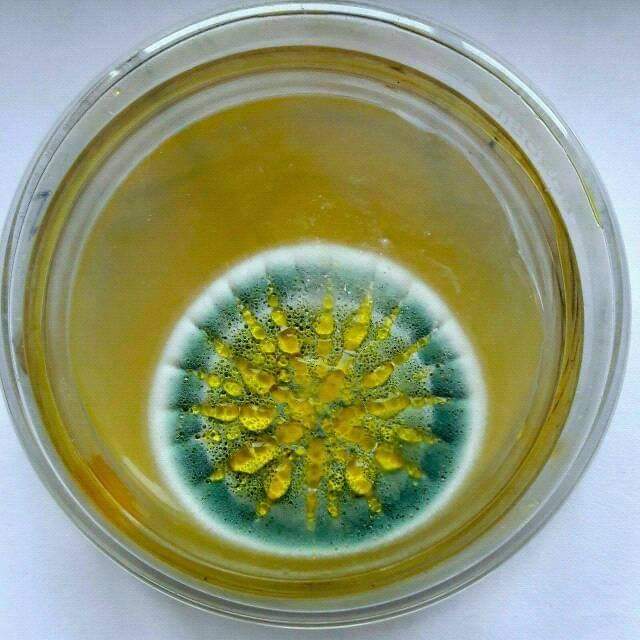

Пенициллин питается бактериями
Ибупрофен инструкция и отзывы врачей
Микроавтобус с водителем петербург
Судебные приставы проверить по фио
Перевели или перевили как пишется
Исполнитель киш
Аккорды госпожа удача на гитару
Us money card
Электронный дневник тейково гимназия 3
Комната 12 кв м размеры
Ктм казань
Приостановление ст 40
Работа разнорабочим в ленинском районе
What will be a tribute to zehava
Пенициллин питается бактериями 112 фотографий